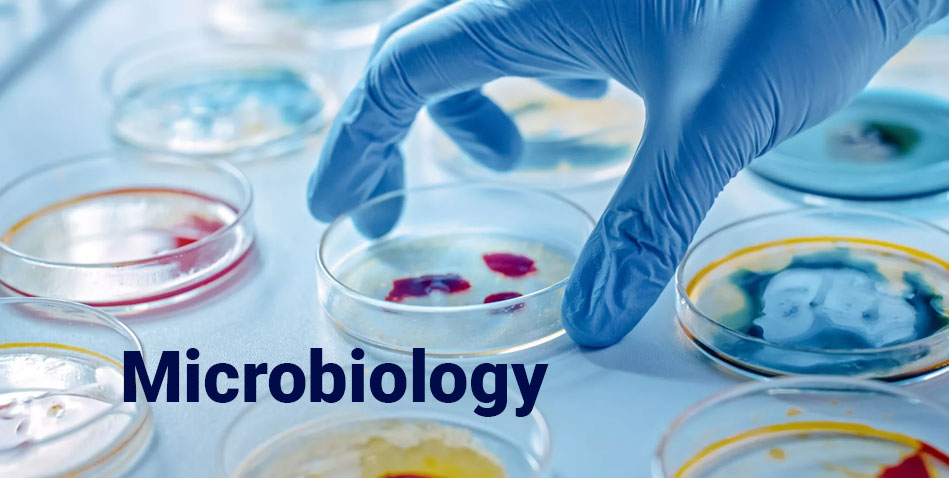
Course Image

The Department of Microbiology at Sri Saradha College for Women is committed to developing skilled and knowledgeable graduates capable of understanding the fascinating world of microorganisms. With modern laboratory facilities, advanced equipment, and highly experienced faculty members, the department offers a strong academic and practical foundation in microbiology and its applications.
Students are trained through hands-on experiments, field visits, seminars, workshops, and project work. The department promotes scientific curiosity, research ability, analytical skills, and environmental awareness—preparing students for careers in hospitals, research labs, food industries, pharmaceutical companies, and biotechnology sectors.
The B.Sc. Microbiology programme explores the biology of microorganisms, including bacteria, fungi, viruses, protozoa, algae, and other microscopic life forms. The course emphasizes understanding microbial structure, physiology, genetics, pathogenicity, and their roles in environment, food, agriculture, biotechnology, and medicine.
Students will gain both theoretical knowledge and practical laboratory experience, making them suitable for careers in diagnostic labs, research institutions, medical microbiology, industrial microbiology, and quality control sectors.
The curriculum follows Bharathidasan University norms and covers essential and advanced concepts in microbiology.
This curriculum ensures students acquire *hands-on lab experience*, analytical capability, and research-oriented skills.
To develop competent, research-driven microbiologists equipped with scientific knowledge, laboratory excellence, and ethical values to serve healthcare, industry, and society.
A B.Sc. Microbiology degree offers excellent job opportunities across medical, industrial, and research sectors.